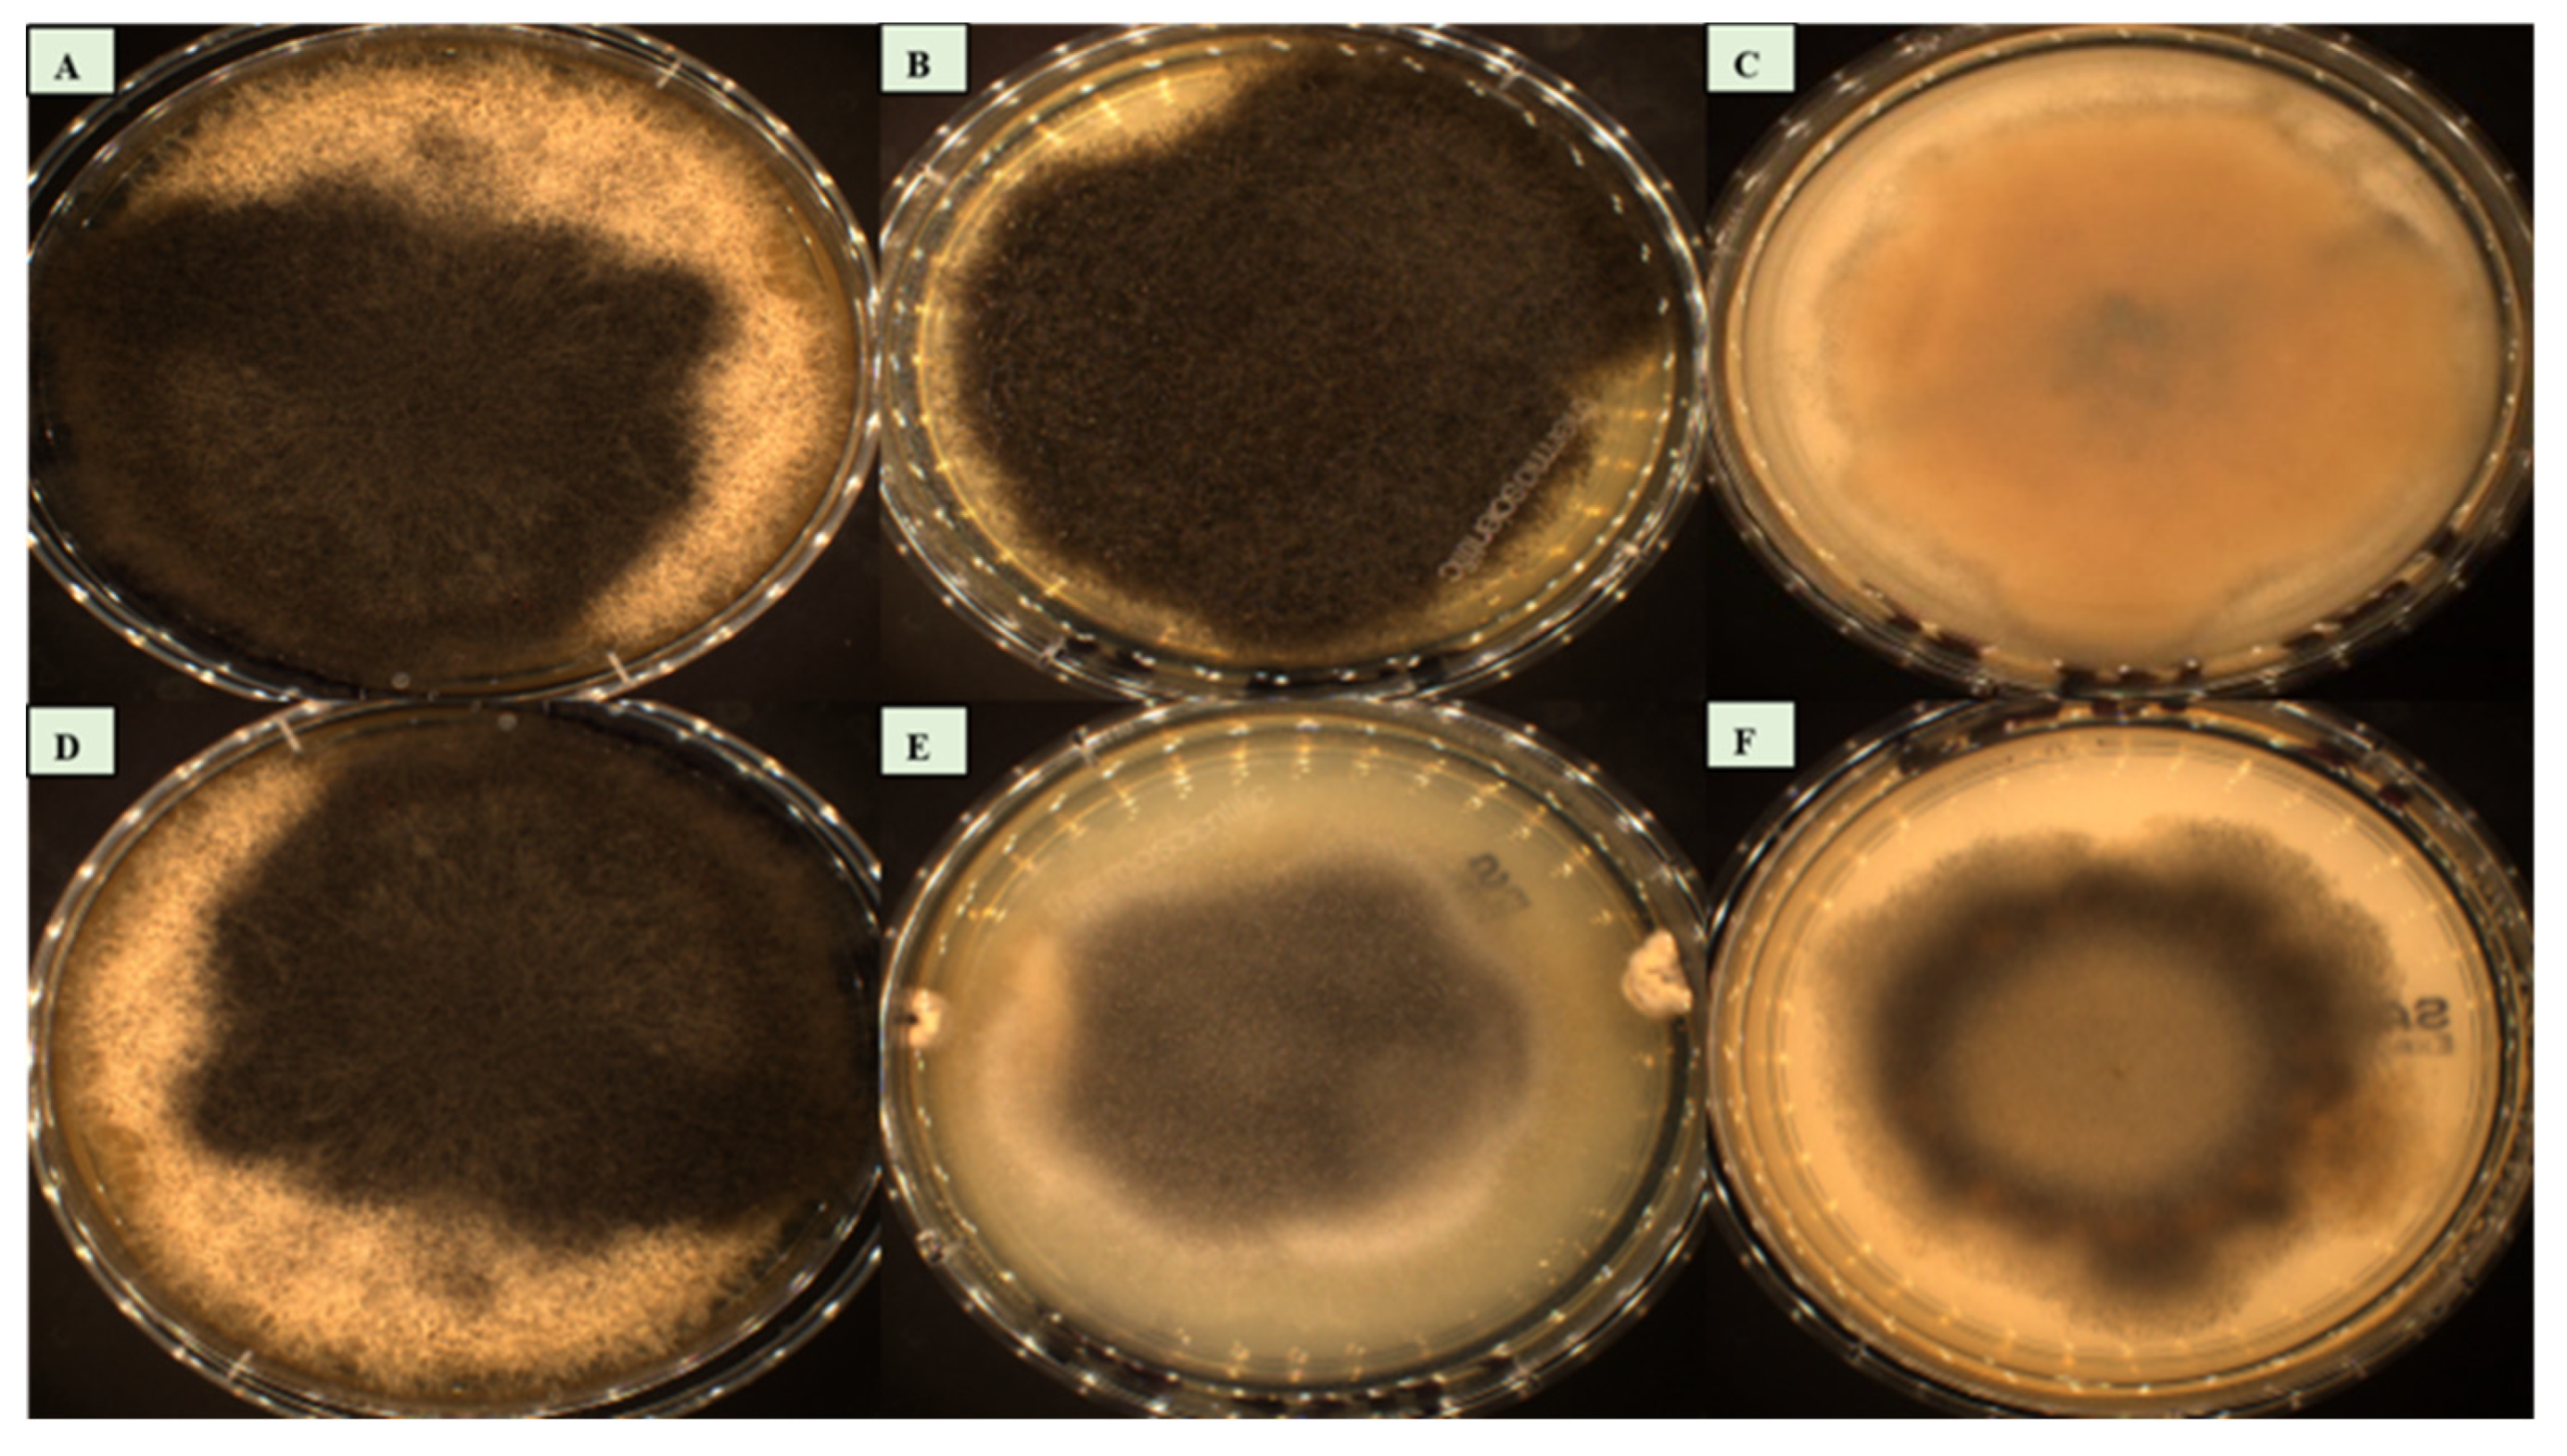

Submitted:
10 October 2023
Posted:
11 October 2023
You are already at the latest version
Abstract
Keywords:
Introduction
Methods
Fungal strains
MALDI-TOF MS identification
DNA extraction
DNA amplification and sequencing
Phylogenetic analysis
Macroscopic characterisation
Microscopic characterisation
Physiological analysis
1. EDX (Energy-Dispersive X-ray Spectroscopy)
2. BiologTM phenotypic analysis
Antifungal Susceptibility Testing (AFST)
Results
MALDI-TOF MS identification
DNA sequencing and phylogenetic analysis
Macroscopic characterisation
Microscopic characterisation
Physiological analysis
1. EDX (Energy-Dispersive X-ray Spectroscopy)
2. BiologTM system
Antifungal Susceptibility Testing (AFST)
Taxonomy
Syncephalastrum massiliense Kabtani J. and Ranque S. sp. nov.
Etymology: Named after Marseille, the city where it was isolated.
Host: Human
Syncephalastrum timoneanum Kabtani J. and Ranque S. sp. nov.
Host: Human
Discussion
Conclusion
Author Contributions
Funding
Acknowledgments
Availability of data and materials
Competing interests
List of Abbreviations
| DNA | deoxyribonucleic acid |
| GC | Gentamycin and Chloramphenicol |
| HIV | Human Immunodeficiency Virus |
| IHU Méditerranée Infection | Institut Hospitalo-Universitaire Méditerranée Infection |
| ITS | rRNA Internal Transcribed Spacers |
| SDA | Sabouraud Dextrose Agar |
| LSU | large-subunit of the rRNA |
| MALDI-TOF MS | Matrix-assisted Laser Desorption/ Ionization Time of Flight Mass Spectrometry |
| MP | Maximum Parsimony |
| NA | Not available |
| PCA | Principal Component Analysis |
| rRNA | ribosomal ribonucleic acid |
| SSU | small-subunit of the rRNA |
| TEF-1-α | partial Translation Elongation Factor 1-alpha gene |
| TUB2 | partial β-tubulin gene |
References
- Amatya, R. ; Khanal, B,; Rijal, A. Syncephalastrum Species Producing Mycetoma-like Lesions. Indian Journal of Dermatology, Venereology, and Leprology. 2010, 3, 76–284. [Google Scholar] [CrossRef]
- Horner, W.E.; Worthan, A.G.; Morey, P.R. Air- and Dustborne Mycoflora in Houses Free of Water Damage and Fungal Growth. Applied and Environmental Microbiology. 2004, 11, 6394–6400. [Google Scholar] [CrossRef]
- Ogunlana, E.O. Fungal Air Spora at Ibadan, Nigeria. Applied Microbiology. 1975, 4, 63–458. [Google Scholar] [CrossRef]
- Rao, C.Y.; Kurukularatne, C.; Garcia-Diaz, J.B.; Kemmerly, S.A.; Reed, D.; Fridkin, S.K.; Morgan, J. Implications of Detecting the Mold Syncephalastrum in Clinical Specimens of New Orleans Residents After Hurricanes Katrina and Rita. Journal of Occupational & Environmental Medicine. 2007, 4, 16–411. [Google Scholar] [CrossRef]
- Ribes, J.A.; Vanover-Sams, C.L.; Baker, D.J. Zygomycetes in Human Disease. Clinical Microbiology Reviews. 2000, 2, 236–301. [Google Scholar] [CrossRef]
- Mangaraj, S.G.S.; Patro, M.K.; Padhi, S. A Rare Case of Subcutaneous Mucormycosis Due to Syncephalastrum Racemosum: Case Report and Review of Literature. Indian Journal of Medical Microbiology. 2014, 4, 51–448. [Google Scholar] [CrossRef]
- Mathuram, A.J.; Mohanraj, P.; Mathews, M.S. ; Rhino-Orbital-Cerebral Infection by Syncephalastrum Racemosusm. The Journal of the Association of Physicians of India. 2013, 5, 40–339. [Google Scholar]
- Baby, S.; Ramya, T.G.; Geetha, R.K. Onychomycosis by Syncephalastrum Racemosum: Case Report from Kerala, India. Dermatology Reports. 2015, 7, 5527. [Google Scholar] [CrossRef]
- Baradkar, V.P.; Mathur, M.; Panda, M.; Kumar, S. Sino-orbital infection by Syncephalastrum racemosum in chronic hepatorenal disease. J Oral Maxillofac Pathol. 2008, 12, 7–45. [Google Scholar] [CrossRef]
- Gomes, M.Z.R.; Lewis, R.E.; Kontoyia, nnis, D. P. Mucormycosis Caused by Unusual Mucormycetes, Non-Rhizopus, -Mucor, and -Lichtheimia Species. Clinical Microbiology Reviews. 2011, 2, 45–411. [Google Scholar] [CrossRef]
- Irshad, M.; Nasir, N.; Hashmi, U.H.; Farooqi, J.; Mahmood, S.F. Invasive Pulmonary Infection by Syncephalastrum Species: Two Case Reports and Review of Literature. IDCases. 2020, 21, 00913. [Google Scholar] [CrossRef]
- Rodríguez-Gutiérrez, G.; Carrillo-Casas, E.M.; Arenas, R.; García-Méndez, J.O.; Toussaint, S.; Moreno-Morales, M.E.; Schcolnik-Cabrera, A.A.; Xicohtencatl-Cortes, J.; Hernández-Castro, R. Mucormycosis in a Non-Hodgkin Lymphoma Patient Caused by Syncephalastrum Racemosum: Case Report and Review of Literature. Mycopathologia. 2015, 2, 89–93. [Google Scholar] [CrossRef]
- Ramesh, V.; Ramam, M.; Capoor, M.R.; Sugandhan, S.; Dhawan, J.; Khanna, G. Subcutaneous Zygomycosis: Report of 10 Cases from Two Institutions in North India: Subcutaneous Zygomycosis. Journal of the European Academy of Dermatology and Venereology. 2010, 10, 25–1220. [Google Scholar] [CrossRef]
- Schlebusch, S.; Looke, D.F.M. Intraabdominal Zygomycosis Caused by Syncephalastrum Racemosum Infection Successfully Treated with Partial Surgical Debridement and High-Dose Amphotericin B Lipid Complex. Journal of Clinical Microbiology. 2005, 11, 27–5825. [Google Scholar] [CrossRef]
- Voigt, K.; Cigelnik, E.; O’donnell, K. Phylogeny and PCR Identification of Clinically Important Zygomycetes Based on Nuclear Ribosomal-DNA Sequence Data. Journal of Clinical Microbiology. 1999, 12, 64–3957. [Google Scholar] [CrossRef]
- Zaki, S.M.; Elkholy, I.M.; Elkady, N.A.; Abdel-Ghany, K. Mucormycosis in Cairo, Egypt: Review of 10 Reported Cases. Medical Mycology. 2013, 1–8. [Google Scholar] [CrossRef]
- Vander, Straten, R. M.; Balkis, M.M.; Ghannoum, A.M. The role of nondermatophyte molds in onychomycosis: diagnosis and treatment. Dermatologic Therapy. 2002, 15, 89–98. [Google Scholar] [CrossRef]
- Gupta, A.K.; Ryder, J.E.; Baran, R.; Summerbell, R.C. Non Dermatophyte Onychomycosis. Dermatologic Clinics. 2003, 2, 68–257. [Google Scholar] [CrossRef]
- Schroter, J. ; Kryptogamen-Flora, von Schlesien: Pilze. Breslau: J.U. Kern. 1908.
- Urquhart, A.S.; Idnurm, A. Syncephalastrum Contaminatum, a New Species in the Mucorales from Australia. Mycoscience. 2020, 3, 15–111. [Google Scholar] [CrossRef]
- Benjamin, R.K. The merosporangiferous Mucorales. Aliso. 1959, 4, 321–433. [Google Scholar] [CrossRef]
- O’Donnell K, Lutzoni F. M.; Ward, T.J.; Benny, G.L. Evolutionary relationships among mucoralean fungi (Zygomycota): evidence for family polyphyly on a large scale. Mycologia. 2001, 93, 286–296. [Google Scholar] [CrossRef]
- Schwarz, P.; Bretagne, S.; Gantier, J.C.; Garcia-Hermoso, D.; Lortholary, O.; Dromer, F.; Dannaoui, E. Molecular identification of zygomycetes from culture and experimentally infected tissue. J. Clin. Microbiol. 2006, 44, 340–349. [Google Scholar] [CrossRef]
- Cassagne, C.; Normand, A.C.; L’Ollivier, C.; Ranque, S.; Piarroux, R. Performance of MALDI-TOF MS Platforms for Fungal Identification. Mycoses. 2016, 59, 90–678. [Google Scholar] [CrossRef]
- Normand, A.C.; Cassagne, C.; Gautier, M.; Becker, P.; Ranque, S.; Hendrickx, M.; Piarroux, R. Decision criteria for MALDI-TOF MS-based identification of filamentous fungi using commercial and in-house reference databases. BMC Microbiol. 2017, 1, 25. [Google Scholar] [CrossRef]
- White, T.J.; Bruns, T.; Lee, S.; Taylor, J. Amplification and direct sequencing of fungal ribosomal RNA genes for phylogenetics. In PCR Protocols. 1990, 18, 22–315. [Google Scholar]
- Glass, N.L.; Donaldson, G.C. Development of Primer Sets Designed for Use with the PCR to Amplify Conserved Genes from Filamentous Ascomycetes. Applied and Environmental Microbiology. 1995, 61, 30–1323. [Google Scholar] [CrossRef] [PubMed]
- Carbone, I.; Kohn, L.M. A Method for Designing Primer Sets for Speciation Studies in Filamentous Ascomycetes. Mycologia, 1999; 91, 553–556. [Google Scholar]
- De Hoog, G.S.; Guarro, J.; Gené, J.; Figueras, M.J. Atlas of Clinical Fungi, 2nd ed.; Universitat Rovira i Virgili Reus: Tarragona, Spain, Ed.; Centraalbureau voor Schimmelcultures: Utrecht, The Netherlands, 2000. [Google Scholar]
- Tamura, K.; Stecher, G.; Kumar, S. MEGA11: Molecular Evolutionary Genetics Analysis Version 11. Édité par Fabia Ursula Battistuzzi. Molecular Biology and Evolution. 2021, 7, 27–3022. [Google Scholar] [CrossRef]
- Kabtani, J.; Militello, M.; Ranque, S. Coniochaeta massiliensis sp. nov. Isolated from a Clinical Sample. J. Fungi. 2022, 8, 999. [Google Scholar] [CrossRef]
- Bochner, B.R. Phenotype MicroArrays for High-Throughput Phenotypic Testing and Assay of Gene Function. Genome Research. 2001, 11, 55–1246. [Google Scholar] [CrossRef]
- Pinzari, F.; Nadir, Abu-Samra, A. C.; Canfora, L.; Maggi, O.; Persiani, A. Phenotype MicroArrayTM System in the Study of Fungal Functional Diversity and Catabolic Versatility. Research in Microbiology. 2016, 9, 22–710. [Google Scholar] [CrossRef]
- Kondori, N.; Svensson, E.; Mattsby-Baltzer, I. In Vitro Susceptibility of Filamentous Fungi to Itraconazole, Voriconazole and Posaconazole by Clinical and Laboratory Standards Institute Reference Method and E-Test: In Vitro Susceptibility of Filamentous Fungi. Mycoses. 2011, 5, 22–318. [Google Scholar] [CrossRef] [PubMed]
- Yang, M.; Lee, J.H.; Kim, Y.K.; Ki, C.S.; Huh, H.J.; Lee, N.Y. Identification of Mucorales From Clinical Specimens: A 4-Year Experience in a Single Institution. Annals of Laboratory Medicine. 2016, 1, 60–63. [Google Scholar] [CrossRef] [PubMed]
- Hoffmann, K.; Pawłowska, J.; Walther, G.; Wrzosek, M.; de Hoog, G.S.; Benny, G.L.; Kirk, P.M.; Voigt, K. The Family Structure of the Mucorales: A Synoptic Revision Based on Comprehensive Multigene-Genealogies. Persoonia - Molecular Phylogeny and Evolution of Fungi. 2013, 30, 57–76. [Google Scholar] [CrossRef] [PubMed]
- Dannaoui, E.; Meletiadis, J.; Mouton, J.W.; Meis, J.F.; Verweij, P.E. In vitro susceptibilities of zygomycetes to conventional and new antifungals. J. Antimicrob. Chemother. 2003, 51, 45–52. [Google Scholar] [CrossRef]
- Torres-Narbona, M.; Guinea, J.; Martinez-Alarcon, J.; Pelaez, T.; Bouza, E. In vitro activities of amphotericin B, caspofungin, itraconazole, posaconazole, and voriconazole against 45 clinical isolates of zygomycetes: comparison of CLSI M38-A, Sensititre YeastOne, and the Etest. Antimicrob. Agents Chemother. 2007, 51, 1126–1129. [Google Scholar] [CrossRef]
- Almyroudis, N.G.; Sutton, D.A.; Fothergill, A.W.; Rinaldi, M.G.; Kusne, S. In vitro susceptibilities of 217 clinical isolates of zygomycetes to conventional and new antifungal agents. Antimicrob. Agents Chemother. 2007, 51, 2587–2590. [Google Scholar] [CrossRef]
- Vitale, R.G.; de Hoog, G.S.; Schwarz, P.; Dannaoui, E.; Deng, S.; Machouart, M.; Voigt, K. Antifungal Susceptibility and Phylogeny of Opportunistic Members of the Order Mucorales. Journal of Clinical Microbiology. 2012, 50, 66–75. [Google Scholar] [CrossRef]

| Primers | Sequences | Targeted regions | References |
|---|---|---|---|
| ITS1 | TCCGTAGGTGAACCTGCGG | 18S-5.8S | [27] |
| ITS2 | GCTGCGTTCTTCATCGATGC | 18S-5.8S | [27] |
| ITS3 | GCATCGATGAAGAACGCAGC | 5.8S-28S | [27] |
| ITS4 | TCCTCCGCTTATTGATATGC | 5.8S-28S | [27] |
| ITS1 | TCCGTAGGTGAACCTGCGG | 18S-5.8S, 5.8S-28S | [27] |
| ITS4 | TCCTCCGCTTATTGATATGC | 18S-5.8S, 5.8S-28S | [27] |
| Bt-2a | GGTAACCAAATCGGTGCTGCTTTC | TUB2 | [28] |
| Bt-2b | ACCCTCAGTGTAGTGACCCTTGGC | TUB2 | [28] |
| EF1-728F | CATCGAGAAGTTCGAGAAGG | TEF1 | [29] |
| EF1-986R | TACTTGAAGGAACCCTTACC | TEF1 | [29] |
| D1 | AACTTAAGCATATCAATAAGCGGAGGA | 28S | [30] |
| D2 | GGT CCG TGT TTC AAG ACG G | 28S | [30] |
| Species | Strain ID | GenBank accession numbers | |||
|---|---|---|---|---|---|
| ITS | TUB2 | D1/D2 | TEF1 | ||
|
Syncephalastrum massiliense |
PMMF0073 | OL699905.1 |
ON149883 |
OM417069.1 | OM362516.1 |
| Syncephalastrum timoneanum | PMMF0107 | OL699906.1 |
ON149884 |
OM417070.1 | OM362517.1 |
| Syncephalastrum racemosum |
DSM 859 |
OL699907.1 |
ON149885 |
OM417071.1 | OM362518.1 |
| S. monosporum var. monosporum |
CBS 567.91 |
OL699908.1 |
ON149886 |
OM417072.1 | OM362519.1 |
| S. monosporum var. cristatum | CBS 568.91 | OL699909.1 | ON149887 | OM417073.1 | OM362520.1 |
| S. monosporum var. pluriproliferum | CBS 569.91 | OL699910.1 |
ON149888 |
OM417074.1 | OM362521.1 |
| Syncephalastrum racemosum | CBS 441.59 | HM999985.1 | NA* | MH869451.1 | NA |
| Syncephalastrum racemosum | CBS 302.65 | HM999984.1 | NA | MH870214.1 | NA |
| Syncephalastrum racemosum | CBS 213.78 | HM999978.1 | NA | MH872886.1 | NA |
| Syncephalastrum racemosum | CBS 421.63 | HM999973.1 | NA | MH869932.1 | NA |
| Syncephalastrum racemosum | CBS 199.81 | HM999972.1 | NA | HM849718.1 | NA |
| Syncephalastrum monosporum | CBS 122.12 | HM999977.1 | NA | JN206575.1 | NA |
| Syncephalastrum racemosum | EML-BT5-1 | KY047152.1 | NA | KY047158.1 | NA |
| Syncephalastrum racemosum | EML-BT5-2 | KY047143.1 | NA | KY047157.1 | NA |
| Microsporum canis | CBS 496.86 | MH861991.1 | NA | NG_069297.1 | NA |
| MIC (mg/l) | AMB | AND | CAS | MIC | 5-FC | FL | ITC | POS | VOR | IS* |
|---|---|---|---|---|---|---|---|---|---|---|
| Syncephalastrum massiliense PMMF0073 | 0.125 | >32 | >32 | >32 | >32 | >256 | 4 | >32 | >32 | >32 |
| Syncephalastrum timoneanum PMMF0107 | 0.047 | >32 | >32 | >32 | >32 | >256 | 1 | 6 | >32 | >32 |
| Syncephalastrum racemosum DSM 859 | 0.25 | >32 | >32 | >32 | >32 | >256 | 0.75 | 0.75 | >32 | >32 |
| S. monosporum var. monosporum CBS 567.91 | >32 | >32 | >32 | >32 | >32 | >256 | >32 | >32 | >32 | >32 |
| S. monosporum var. cristatum CBS 568.91 | >32 | >32 | >32 | >32 | >32 | >256 | >32 | >32 | >32 | >32 |
| S. monosporum var. pluriproliferum CBS 569.91 | >32 | >32 | >32 | >32 | >32 | >256 | >32 | >32 | >32 | >32 |
Disclaimer/Publisher’s Note: The statements, opinions and data contained in all publications are solely those of the individual author(s) and contributor(s) and not of MDPI and/or the editor(s). MDPI and/or the editor(s) disclaim responsibility for any injury to people or property resulting from any ideas, methods, instructions or products referred to in the content. |
© 2023 by the authors. Licensee MDPI, Basel, Switzerland. This article is an open access article distributed under the terms and conditions of the Creative Commons Attribution (CC BY) license (http://creativecommons.org/licenses/by/4.0/).




